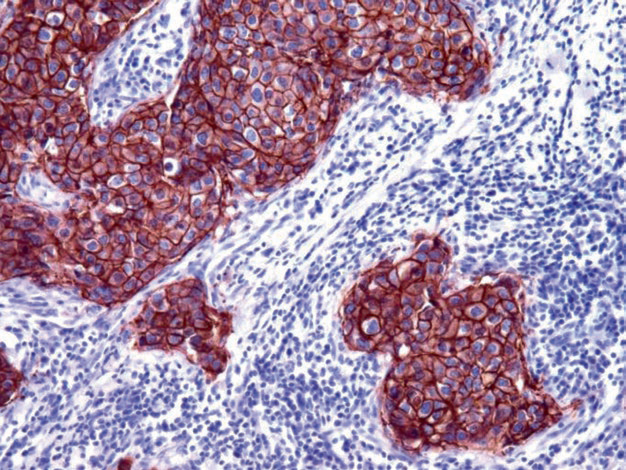

正常乳腺组织包括了间质成分和上皮成分,而上皮成分又可分为导管、腺泡、肌上皮三种不同细胞类型。不同成分的免疫表型各有特点,因此来源于不同成分的肿瘤其免疫表型也各有差异,这是乳腺肿瘤免疫组化检测的重要理论基础。此外,乳腺肿瘤性病变形态学多样,因此实际工作中应根据不同目的有针对性的选择相关指标。具体详见表1-3。
表1. 乳腺导管上皮增生及原位癌的免疫组化特点

(点击可查看大图)
备注:
中间型肌上皮细胞在管腔面缺失或仅有少许残余,免疫组化阳性指标为CK5/6、CK14;基底处肌上皮完整,免疫组化阳性指标为CK5/6、CK14、p63、Actin、myogenin、h-caldesmon、calponin。
正常肺肿瘤性乳腺小叶细胞为E-cadherin阳性。
表2. 乳腺浸润性癌免疫组化特点

(点击可查看大图)
备注:
典型的髓样癌中,ER和PR一般为阴性。
表3. 其他部分乳腺肿瘤免疫组化特点

(点击可查看大图)
ER是类固醇激素受体家族成员,具体包括了由不同基因编码的两种类型- ER-α和ER-β。不同类型的ER在人体不同器官和组织中的分布有一定差异:ER-α主要表达于乳腺、子宫、胎盘、肝脏、中枢神经系统、血管内皮、骨组织等处的上皮和间质细胞,而ER-β主要表达于前列腺、睾丸、卵巢、脾脏、胸腺、皮肤、内分泌腺(如甲状腺、甲状旁腺、肾上腺、胰腺)。当然,也有很多组织会同时表达两种类型的ER。根据前述资料,ER的表达可作为判定大部分乳腺癌、以及某些子宫和卵巢来源癌的较好免疫组化标记。对于所有的类固醇受体标记来说,除细胞核着色外的其他着色方式均应解读为阴性。乳腺癌中ER-α的表达还具有内分泌治疗效果预测的意义;ER-α是否表达,对于其他治疗方案的选择以及患者预后也有一定指导意义。目前对于ER和PR有几项半定量评分方案,其评分体系基本都是根据细胞核着色强度和阳性肿瘤细胞比例来进行计算。2019年第五版乳腺肿瘤世界卫生组织著作中,对于ER-α的评估原则为:只需1%的肿瘤细胞为弱阳性,即可评估为阳性,因为有证据表明这一组病例也可能自内分泌治疗而获益。不过,肿瘤细胞阳性比例1-10%的浸润性癌应报告为低水平阳性(low positive)并做进一步备注。同时,鉴于ER在乳腺癌中表达的异质性,因此应注意报告阳性细胞占所有浸润性癌成分的比例;如果阳性程度有差别,还应注意综合评估阳性着色的整体情况
图1. 乳腺癌,ER在细胞核强阳性表达。
乳腺癌中ER的表达情况与肿瘤组织学类型、分化程度有关。此外,ER的表达并不仅限于上述器官和组织类型,也可能会在其他肿瘤表达,具体如肝细胞肝癌、移行细胞癌。因此实际应用中诊断原发乳腺癌时,应注意加做更多标记,如GATA-3、Mammaglobin、GCDFP-15、PR以及部分CK。
孕激素是一种类固醇激素,与乳腺实质及子宫内膜的分化有关。PR是一种较好的乳腺癌标记,由于该指标在非乳腺癌仅有少数瘤种表达,因此用于乳腺癌诊断时的敏感性要优于ER。与ER相似,PR的表达和肿瘤的分化程度有关;高级别癌的激素受体多为阴性。同时,PR的状态对于乳腺癌、子宫内膜癌、卵巢癌也是一种重要的预后指标。ER和PR高水平表达,对于乳腺癌和子宫内膜癌来说,意味着内分泌治疗效果较好。
HER-2分子是正常上皮细胞细胞膜的一部分,其受体数量较少。发生癌的时候,位于17号染色体上的HER-2基因扩增导致肿瘤细胞细胞膜上的相应指标过表达。不过,这一特点仅见于少数肿瘤类型,主要是乳腺癌、胃腺癌、少数其他的癌,后者如卵巢癌、肺的非小细胞肺癌、腺癌癌、尿道的移行细胞癌。HER-2基因的扩增可进行FISH检测。由于免疫组化可以简单的评估肿瘤细胞细胞膜上HER-2分子的过表达,因此也可以通过特异性抗体做到半定量检测。HER-2免疫组化结果已成为乳腺癌及其他HER-2阳性癌治疗中的重要指标。为精确评估HER-2表达情况,应注意下述几个问题:用于HER-2免疫组化检测的组织必须极好的固定;
免疫组化结果的评估必须对照得分为0、1+、3+的标准质控切片进行;
只有膜着色才记为阳性,细胞质或细胞核的着色必须忽略,免疫组化中的边缘人工假象着色也要忽略;
只评估肿瘤的浸润性成分。
图2. 乳腺癌,本图中所有肿瘤细胞均为HER-2强阳性表达,评分为3+。关于乳腺癌HER-2评分具体标注及相关结果的解读、进一步处理,请参阅最新版相关指南。需要注意的是,HER-2并非乳腺组织及乳腺癌的特异性标记,且乳腺癌中也仅有30%会有HER-2的过表达,主要为非特殊类型的高级别癌。
GATA-3参与乳腺管腔上皮增生及分化的调节,也参与T淋巴细胞和皮肤附属器的分化。临床实践中,GATA-3广泛应用于原发及转移性的乳腺癌、移行细胞癌诊断和鉴别诊断。高达90%的乳腺癌会表达GATA-3,但三阴型乳腺癌中的阳性率最低,化生性乳腺癌、肉瘤样乳腺癌中的阳性率也较低。男性乳腺癌中,GATA-3阳性率仅为三分之一。乳腺癌中GATA-3强阳性表达也会伴有ER的表达;GATA-3高表达,一般意味着预后较好。

图3. 乳腺浸润性导管癌,骨转移灶;免疫组化肿瘤细胞的细胞核强阳性表达GATA-3。
如前所述,GATA-3还可应用于原发及转移性移行细胞癌的诊断和鉴别诊断,本系列文章后面会有详述。不过,除此之外还有多种组织和肿瘤会表达GATA-3,具体解读中应注意避免陷阱。具体来说,间皮瘤、不同器官的鳞状细胞癌、胰腺导管腺癌、皮肤附属器肿瘤、多种良性及恶性涎腺肿瘤(如涎腺导管癌、腺泡细胞癌、腺样囊性癌、上皮肌上皮癌)中会有不同程度的GATA-3表达。也有报道称,少数子宫内膜癌会表达GATA-3。GATA-3的表达也是T淋巴细胞和外周T细胞淋巴瘤的特征。值得注意的是,反应性间皮中也会有GATA-3的表达。也正是因为有上述这些问题,所以GATA-3用于乳腺肿瘤和尿路上皮肿瘤诊断时应注意其特异性问题。
Mammaglobin是一种低分子量蛋白,针对该蛋白的单克隆抗体是乳腺来源肿瘤的较好标记物:原发乳腺癌及淋巴结转移灶中,80-90%的病例会表达这一标记。与其他乳腺标记物一样,Mammaglobin的表达并不仅限于乳腺组织及相应肿瘤,也可见于其他肿瘤类型,如子宫内膜样癌、汗腺癌、涎腺肿瘤、少数胆管细胞癌、肺腺癌。间皮瘤并不表达Mammaglobin。该蛋白表达于大汗腺细胞或伴大汗腺化生的细胞,受雄激素受体调节。所以该抗体可以表达于多部位的大汗腺细胞及相关肿瘤。乳腺导管和小叶细胞并不表达GCDFP-15。乳腺癌中GCDFP-15的阳性率在不同研究中也并不一致,一般为30%至90%不等。三阴型乳腺癌一般并不表达GCDFP-15。
GCDFP-15也可表达于其他大汗腺、小汗腺、浆液腺的腺上皮及这些腺体来源的癌,如皮肤附属器肿瘤;在鉴别皮肤原发肿瘤与转移性乳腺癌时应注意考虑。
E-cadherin是一种跨膜糖蛋白,属于钙依赖性细胞黏附分子中的主要成员。E-cadherin的表达与上皮复层化、极向化有关,也与腺体形成有关。E-cadherin表达于多种类型的上皮细胞及相关的癌。常规组织病理学中,E-cadherin用于鉴别乳腺导管癌和小叶癌:乳腺小叶肿瘤不表达E-cadherin。乳腺小叶肿瘤中E-cadherin表达缺失,导致胞质内p120 catenin的蓄积,也可作为乳腺小叶癌的标记。E-cadherin还可用于反应性间皮增生和间皮瘤的鉴别,前者一般为阴性而后者一般为阳性。E-cadherin还可作为多种类型癌的预后指标,如乳腺癌、移行细胞癌,因为E-cadherin表达的缺失与侵袭性行为有关。该指标是乳腺分化抗原,表达于正常乳腺上皮及60%的乳腺癌。免疫组化表达模式为细胞质着色,偶见细胞核着色;其着色强度与肿瘤分化程度、ER的表达程度有关。大汗腺、约三分之一的大汗腺肿瘤也可表达NY-BR-1。
迈迈:“E-Cadherin几乎在所有的导管原位癌和浸润癌中阳性表达,而在小叶原位癌和浸润癌中常为阴性,联用p120可用于乳腺导管癌与小叶癌的鉴别诊断。而ER和PR阳性的肿瘤患者大多数内分泌治疗有效,且缓解率高、复发率低、预后好。ER常与PR和HER-2一起作为乳腺癌患者的常规检查项目。Mammaglobin在乳腺组织中有较高特异性,在80%的乳腺癌中阳性表达,联用GCDFP-15可用于乳腺癌的诊断。”
抗体名称 | 克隆号 | 阳性对照 | 阳性部位 |
E-Cadherin* | MX020 | 乳腺导管浸润癌、肝脏
| 胞膜/胞质 |
ER | SP1 | 乳腺癌、宫颈 | 胞核 |
GATA-3 | L50-823 | 尿路上皮癌、乳腺癌
| 胞核
|
GCDFP-15 | 23A3 | 涎腺组织、乳腺组织 | 胞质 |
HER-2* | MXR001 | 乳腺导管浸润癌
| 胞膜
|
Mammaglobin | 304-1A5 | 乳腺组织 | 胞质 |
PR | SP2 | 乳腺癌、子宫内膜
| 胞核
|
更多信息,请详询:800-8581156或400-889-9853